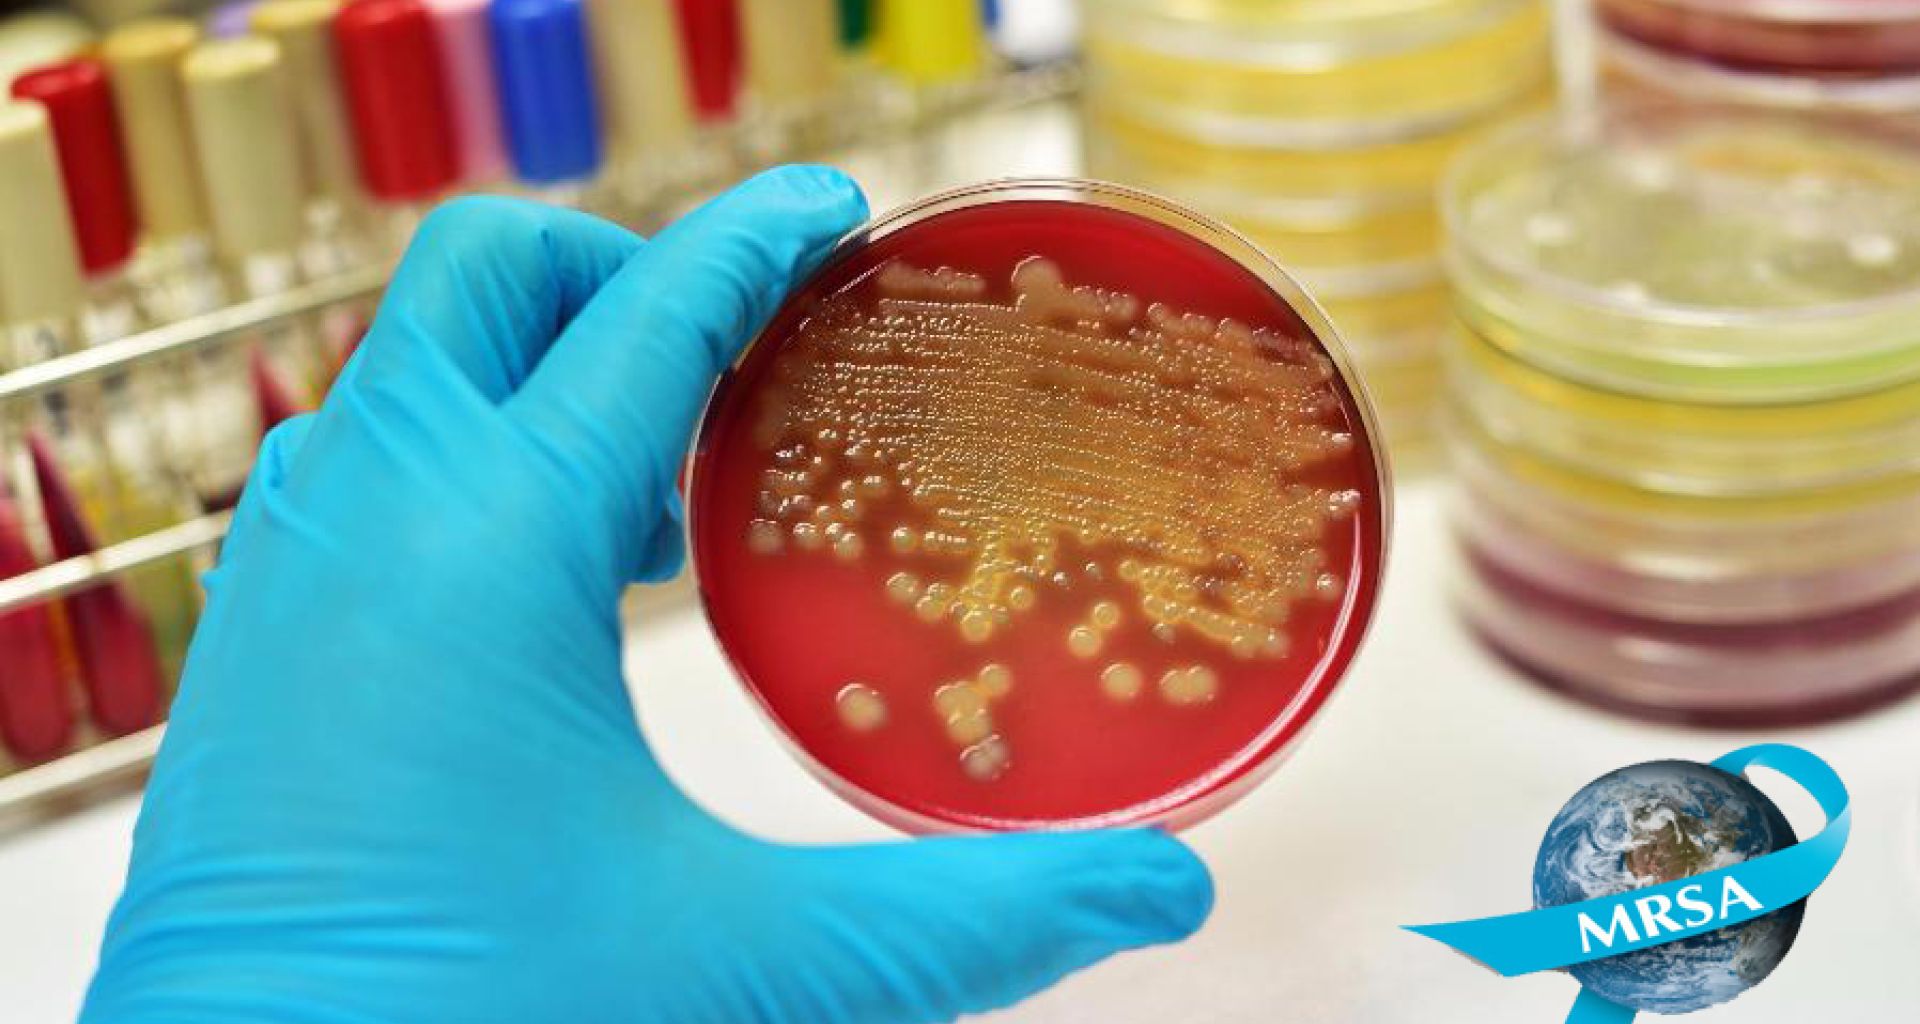
هل هناك داعي للقلق من هذه النتائج...؟ 8 هل هناك داعي للقلق من هذه النتائج…؟

هل هناك داعي للقلق من هذه النتائج…؟
خلال العقود الماضية أصبحت البكتيريا المعروفة بأختصار المرسا (MRSA) وهي بكتيريا العنقوديات الذهبية المستعصية على الميثيسيلين (Methicillin-resistant Staphylococcus aureus) من أكثر أنواع البكتيريا المعندة إزعاجاً للوسط الطبي وللأطباء في علاجهم للمرضي وأكثر أنواع البكتيريا المطفرة والمتحولة من بكتيريا مسالمة إلى بكتيريا شديدة الأمراضية ومقاومة للعديد من المضادات وقاتلة في العديد من الأحيان، هذه البكتيريا سببت […]
خلال العقود الماضية أصبحت البكتيريا المعروفة بأختصار المرسا (MRSA) وهي بكتيريا العنقوديات الذهبية المستعصية على الميثيسيلين (Methicillin-resistant Staphylococcus aureus) من أكثر أنواع البكتيريا المعندة إزعاجاً للوسط الطبي وللأطباء في علاجهم للمرضي وأكثر أنواع البكتيريا المطفرة والمتحولة من بكتيريا مسالمة إلى بكتيريا شديدة الأمراضية ومقاومة للعديد من المضادات وقاتلة في العديد من الأحيان، هذه البكتيريا سببت قلق عالمي متزايد وأصبحت الشغل الشاغل لفرق مكافحة العدوى داخل المستشفيات.
هذا القلق كان نتيجة طبيعية بسبب زيادة مقاومة العديد من المضادات الحيوية المعروفة والمتوفرة، وكذلك من حيث سهولة أنتشارها ما بين المرضى والعاملين في كل المستشفيات بدول العالم بدون تمييز الغنية والفقيرة، وأحياناً كثيرة يكون أنتشارها بطريقة وبائية سريعة من الصعب إحتوائها والقضاء عليها، بالإضافة للمشاكل الصحية المعقدة والوفيات الكثيرة الناتجة عنها (Morbidity and Mortality) وخاصة داخل الأقسام العلاجية الحيوية مثل وحدات العناية الفائقة وأقسام الجراحة وأجنحة الأيواء بالمستشفيات. (De Lencastre H et al., 2007)، (Hawkins G, et al., 2011)،(Cookson b, et al., 1989)، (Vonberg RP, et al., 2006)
حالياً تعتبر المرسا (MRSA) إحدى أشهر البكتيريا في ما يعرف بعدوى المستشفيات (Nosocomial Infection) وهي العدوى التي تنشاء بواسطة ميكروبات ممرضة داخل المستشفى تحدث للمرضى النزلاء بعد دخولهم للعلاج من مرض أخر، ويعتبر العاملين في قطاع الصحة (Healthcare Worker, HCEWs) حسب الدراسات العلمية من أهم مصادر نقل العدوى ما بين المرضى في المستشفيات ببكتيريا المرسا (MRSA). لمدد قريبة كانت الإصابات ببكتيريا المرسا معظمها يحدث فقط في المستشفيات (Hospital-acquired Infection) ولكن حاليا أصبح من الممكن أكتساب الإصابة في المستشفيات وفي المجتمع كذلك (Community- acquired Infection) مما زاد من خطورة هذه البكتيريا وزاد من القلق العالمي بالخصوص. (Groom AV et al., 2001)، (Robinson JO et al., 2009)، (AL-Abdli and Baiu, 2014).
يعتبر منع والتحكم في انتشار بكتيريا المرسا (MRSA) من أكبر التحديات التي تواجه المستشفيات في كل دول العالم.

بصفة عامة، تعتبر بكتيريا المرسا (MRSA) من ضمن أكثر أنواع الميكروبات التي عزلت من العاملين في الصحة ففي خلال دراسة مرجعية كبيرة (Albrich and Harbarth, 2008) درست فيها نتائج 127 بحث علمي منشور على مستوى العالم عن أنتشار بكتيريا المرسا (MRSA) في العاملين بالصحة ذكرا بأن نسبة تواجد هذه البكتيريا عالمياً لدى العاملين في وحدات العناية الفائقة يصل إلى 4.7% أما نسبة تواجدها في أيدي العاملين فيصل إلى 6.4%، ونسبة تواجدها في العاملين بالصحة في دول الشرق الأوسط هو 6.1%.
كانت هذه البكتيريا في السابق من السهل علاجها بالمضاد الحيوي الميثيسيلين والكثير من الأشخاص يعتبرون ناقل طبيعي لها حتى أكتسبت البكتيريا بطريقة أو أخرى الجينات مقاومة للمضاد الحيوي حيث يرجع السبب الرئيسي في ذلك للأستهلاك المفرط لشتى أنواع المضادات الحيوية وخاصة داخل المستشفيات.
في هذه المقالة سنناقش سبعة دراسات بحثية حديثة أجرها بحٌاث ليبين تكلمت عن نسبة تواجد بكتيريا المرسا (MRSA) في العاملين بالصحة في المستشفيات الليبية في عدة مدن ليبية وذلك لمعرفة حجم أنتشار هذا الميكروب بينهم وهل النتيجة التي توصل إليها البٌحاث تدعو للقلق على سلامة المرضى بالمستشفيات وما هي الحلول والأجراءات الواجب إتخاذها للحد أو التقليل من هذه المشكلة إذا كانت النتائج مرتفعة.
الدراسة الأولى:
أجري الزرقاني والأخرون (Zorgani A et al., 2009) أول دراسة شاملة لمعرفة نسبة تواجد بكتيريا المرسا (MRSA) في العاملين بالصحة في ستة مستشفيات ليبية كبري بمدينة طرابلس، أخذت عينات من مقدمة فتحة الأنف (anterior nasal swab) من 643 عامل بالصحة حيث شملت الدراسة 196 طبيب وطبيبة، 447 ممرض وممرضة يعملون في وحدات العناية الفائقة وأقسام الجراحة. حيث وجد الزرقاني والأخرون أن 237 (36.8%) من العاملين كانت نتيجتهم موجبة لوجود بكتيريا المرسا (MRSA) بنسب 33% أطباء و 39% طواقم تمريض، وكانت نسبة تواجد بكتيريا المرسا في العاملين بوحدة العناية الفائقة هي 42% بينما في أقسام الجراحة كانت 27%. كما أن الدراسة ذكرت أن نسبة تواجد بكتيريا المرسا (MRSA) في طاقم التمريض لوحدات العناية الفائقة (46%) أكثر من طاقم التمريض بأقسام الجراحة (26%).
الدراسة الثانية:
بعد سنة واحدة من الدراسة الأولى أجريت دراسة ثانية من قبل أبوالقاسم وأخرون (Belgasim Z. et al., 2010) عن نسبة تواجد بكتيريا المرسا (MRSA) في العاملين. وهذه الدراسة ركزت فقط على مرفق صحي واحد وهو المركز الأفريقي للأورام والذي يعتبر من أحد أهم المراكز الليبية الرئيسية لتشخيص وعلاج الأورام بمدينة صبراته شمال غرب ليبيا. أخذت مسحات من الأنف (anterior nasal swab) وبصمة السبابة (fingertip cultures) لعدد 43 عينة منها 15 طبيب وطبيبة و 28 ممرض وممرضة بصالات العمليات ووحدة العناية الفائقة.
وجدت البكتيريا في خمسة عاملين بنسبة 11.6% منهم 2 تم عزل البكتيريا من الأنف والأصبع أم حالتين من الأصبع فقط وحالة واحدة من الأنف. كانت نسبة تواجد البكتيريا لدى الأطباء هي 3 من 15 (20%) اما طاقم التمرض فكانت 2 من 28 (7.14%) مما يدل على أن الأطباء هم أكثر الحاملين للبكتيريا من طاقم التمريض والتي وجدت البكتيريا في أصابعهن فقط.
الدراسة الثالثة:

الدراسة الرابعة


الدراسة الخامسة
في دراسة أجريت سنة 2014 (Al-haddad OH, Zorgani A, and Ghenghesh KS. 2014) تمت دراسة نسبة تواجد بكتيريا المرسا في الأطفال المرضى النزلاء بمستشفى الأطفال بمدينة طرابلس حيث أخذت مسحات من الأنف وكذاك من أمهات الأطفال والعاملين في المستشفى (87 طبيب، 82 ممرضة، 9 عاملة نظافة) وقد أخذت عينات للمقارنة من أطفال مرضى زوار من خارج المستشفى . تم التأكد من العينات عبر الأختبارات القياسية للتعرف على بكتيريا المرسا (MRSA) مع استعمال مزارع الكروموجينك الخاصة بالبكتيرا المرسا (Chromogenic MRSA ID Medium) وتأكيدها بواسطة أختبار (PCR) فكانت النتائج كالتالي: نسبة النتائج الموجبة لوجود بكتيريا المرسا في الأطفال النزلاء (8.3٪، 24 من 289) وأمهاتهم (11٪، 22 من 200) وكانت نسبة تواجدها في العاملين في مجال الرعاية الصحية (12.4٪، 22 من 178)، وهي نتائج تعتبر عالية بالمقارنة بنسبة تواجد البكتيريا في الأطفال المرضى من خارج المستشفى (2.2٪ ، 2 من 91).
الدراسة السادسة

الدراسة السابعة


بسبب أرتفاع وجود بكتيريا المرسا (MRSA) في المستشفيات الليبية الأمر الذي يجبر الدولة على تطبيق برامج مكافحة العدوى في كل المستشفيات الليبية للحد والتقليل من أنتشار الميكروبات الممرضة المعندة (antimicrobial-resistant pathogens) بداخل المستشفيات.
هل هناك داعي لقلق من هذه النتائج…؟
من خلال مراجعة الدراسات السابقة المذكورة والتي أجريت لتحديد نسبة تواجد بكتيريا المرسا (MRSA) في العاملين بالصحة بالمستشفيات الليبية في عدة مدن (طرابلس، بنغازي، صبراتة، الخمس) ومستشفيات مختلفة كانت هذه النقاط الرئيسية التي توصلت إليها الدراسات:
1- بوجه عام، تعتبر النتائج التي تحصل عليها الباحثون عالية جدا وهذا الأمر يدعو للقلق الكبير على سلامة المرضى في الأقسام العلاجية من انتقال العدوى لهم من العاملين في الصحة خلال فترات العناية بهم.
2- عزلت هذه البكتيريا من كل الأقسام العلاجية بالمستشفيات بدون أسثتناء وأكثر الأقسام تواجد فيها الميكروب هي الأقسام الحيوية وذات الخطورة الكبيرة مثل وحدات العناية الفائقة وأقسام الجراحة وعلاج الأورام وهذا يزيد من أمكانية نقل هذه البكتيريا ما بين المرضي ضعيفي المناعة (immunocompromised patients) والنزلاء بوحدات العناية الفائقة والأنعاش وكذلك المرضى الذين يتعاطون أدوية العلاج الكيماوي لأمراض السرطان.
3- عزل بكتيريا المرسا من العاملين بالصحة في المستشفيات الليبية ربما تتأثر بالعديد من العوامل وربما تحتاج الدراسات التي ذكرت بالمقالة لعديد من العينات لنفس الشخص وفي أوقات مختلفة وأماكن من الجسم مختلفة وليست فقط عينة واحدة فهذا سيثبت إذا كانت البكتيريا ساكن طبيعي ومقيمة بالجسم (Persistent) أو انها فقط بكتيريا زائرة (Transient)، وهذا يفيد في أختيار طرق مكافحة الميكروب.
4- في معظم الدراسات اكد الباحثين بأنه لا يوجد دليل أو إجراءات ولوائح صارمة بخصوص عملية نظافة اليدين (hand hygiene) وأن استعمال الكحول لليدين غير معمول به بطريقة روتينية وأن الأمثثال لعمليات نظافة اليدين قليل جدا.
وفي الختام، ولكل ما سبق وللإجابة عن السؤال الموجود في العنوان..نعم هناك داعي للقلق بخصوص هذه النتائج.. وقلق كثير جدا…! أنها نتائج محرجة وتحتاج منا جميعاً للتحرك بسرعة…
لهذا يجب إتباع التوصيات التي أختصرتها تحت للحد من هذه المشكلة ومنع تفاقمها، وهذا ما قامت به العديد من الدول التي أحست بخطر هذا الميكروب على مواطنيها…
توصيات
1- تفرض هذه النتائج على وزارة الصحة وصانعي القرار في ليبيا ضرورة وضع مخطط عام وتطبيق برامج مكافحة العدوى في داخل مستشفيات وإجبار مدراء المستشفيات بذلك للحد والتقليل من أنتشار الميكروبات الممرضة المعندة (antimicrobial-resistant pathogens) بداخل المستشفيات.
2- وضع برنامج وطني لمراقبة عدوى السلالات البكتيريا المقاومة للمضادات الحيوية بصفة عامة على أن يتم التركيز على الأنواع التي بها خطورة كبيرة مثل بكتيريا المرسا (MRSA) وغيرها، على أن يكون هذا البرنامج إلزامي للمرافق الصحية جميعاً، وأن يتم التنسيق والربط مع الشبكات الدولية لتوحيد جهود الرصد والمكافحة فهذا سيحفز مداركنا لفهم ومعرفة أكثر لمدى أنتشار هذه الميكروبات وبالتالي للوصول إلى طرق ناجعة لمكافحة الميكروب.
3- يجب على وزارة الصحة وصانعي القرار وضع برنامج وطني لمراقبة المضادات الحيوية بهذف التقليل من البكتيريا المقاومة للمضادات الحيوية عن طريق تقنين أستهلاك المرضى والمواطنين في المضادات الحيوية والتحكم في تجارتها وأستيرادها وتوزيعها وألا يترك للأفراد وللشركات التجارية الخاصة فقط، ايضا مراقبة آلية صرف المضادات الحيوية بداخل المستشفيات للحد من خلق ميكروبات مضادة للأدوية.
4- العديد من الدراسات نوهت إلى ضرورة الكشف الدوري عن تواجد بكتيريا المرسا (MRSA) في العاملين بالصحة بشكل روتيني حتى يتم معالجة الحاملين للميكروب او أستبعادهم مؤقتا عن الأقسام الحيوية الخطيرة حتى لا يحدث أنتشار أوسع للميكروب بين المرضى وداخل بيئة المستشفيات، وخاصة العاملين في الأقسام الحيوية التي تحتوى على مرضى نزلاء ضعيفي المناعة و يحتاجون للعناية فائقة، وخاصة العاملين من يحملون البكتيريا كساكن طبيعي دائم.
4- المزيد من الدراسات مطلوبة حول المرسا (MRSA) لمعرفة العديد من الاشياء التي لها علاقة بمقاومة البكتيريا للمضادات الحيوية وايضا طرق انتشارها بين المرضى وتسببها في حدوث الأمراض المعدية، هذه الدراسات تفيد الأطباء وإخصائي الوبائيات والوقاية من العدوى.
5- يجب وضع برامج لمراقبة الجودة (Quality Control Programs) في معامل التحاليل للأحياء الدقيقة بداخل المستشفيات وتدريب العاملين بهذه المختبرات على الطرق القياسية لعزل والتعرف على البكتيريا المقاومة للمضادات الحيوية، على أن يتم وضع برنامج للتبليغ عن الحالات الجديدة المعزولة وتدرج في قاعدة بيانات حتى تصبح دليل للجهات المختصة في برامج مكافحة العدوى على مستوى الدولة.
References:
Ahmed MO, et al., (2012). Isolation and screening of methicillin- resistant Staphylococcus aureus from health care workers in Libyan hospitals East. Mediterr Health. J. 2012;18(1):37-42.
Ahmed MO, et al. (2010). Misidentification of methicillin resistant Staphylococcus aureus (MRSA) in hospitals in Tripoli, Libya. Libyan J Med 2010, 5: 5230
AL-Abdli NE. and Baiu SH. (2014). Nasal Carriage of Staphylococcus in Health Care Workers in Benghazi Hospitals. American Journal of Microbiological Research, Vol. 2, No. 4, 110-112
Albrich WC and Harbarth S. (2008). Health care workers: source, vector, or victim of MRSA? Lancet Infect. Dis. ;8:289-301.
Al-haddad OH, Zorgani A, and Ghenghesh KS. (2014). Nasal Carriage of Multi-Drug Resistant Panton-Valentine Leucocidin-Positive Methicillin-Resistant Staphylococcus aureus in Children in Tripoli-Libya. Am. J. Trop. Med. Hyg., 90(4), 2014, pp. 724–727
Belgasim Z, Saadaoui A, Zorgani A. (2010). Screening for methicillin resistant Staphylococcus aureus among health care workers in the African Oncology Institute, Sabrata-Libya. American Journal of Infection Control, 38:498–499.
Cookson B, et al., (1989). Staff carriage of epidemic methicillin-resistant Staphylococcus aureus. J Clin Microbiol;27:1471-6.
De Lencastre H et al. (2007). Antibiotic resistant Staphylococcus aureus: a paradigm of adaptive power. Current Opinion in Microbiology, 2007, 10:428–435.
Doro B. et al. (2016). Prevalence of Methicillin-resistant Staphylococcus aureus among Health Care Workers in Tripoli Hospital, Libya. British Microbiology Research Journal. 14(1): 1-7.
Groom AV et al. (2001). Community-acquired methicillin-resistant Staphylococcus aureus in a rural american indian community. Journal of the American Medical Association, 286:1201–1205.
Hawkins G et al. (2011). Should healthcare workers be screened routinely for methicillin-resistant Staphylococcus aureus? A review of the evidence. Journal of Hospital Infection 77 (2011) 285-289
Krima HM. (2016). Antibiotic susceptibility pattern of mrsa isolates from the staffs of al-khoms teaching hospital, libya. World journal of pharmacy and pharmaceutical sciences. Volume 5, Issue 5, 100-106
Robinson JO et al. (2009). Community-associated versus healthcare associated methicillin-resistant Staphylococcus aureus bacteraemia: a 10-year retrospective review. European Journal of Clinical Microbiology & Infectious Diseases, 28:353–361.
Vonberg RP, et al. (2006). How often do asymptomatic healthcare workers cause methicillin-resistant Staphylococcus aureus outbreaks? A systematic evaluation. Infect Control Hosp Epidemiol. ;27:1123-7.
Zorgani A et al. (2009). Detection of meticillin-resistant Staphylococcus aureus among healthcare workers in Libyan hospitals. Journal of Hospital Infection, 2009, 73:91–92.
كلمة شكر: كل الشكر للزميل والصديق الأستاذ الدكتور عبد العزيز الزرقاني قسم الأحياء الدقيقة، كلية الطب البشري، جامعة طرابلس لتكرمه بأعطائي نسخ من بعض دراساته القيمة في عزل بكتيريا المرسا من العاملين في مجال الصحة. أ.د عبد العزيز الزرقاني من البحاث الأوائل اللذين ساهموا بشكل كبير في دراسة وإجراء البحوث القيمة على هذه البكتيريا ومدى أنتشارها في العاملين بالمستشفيات الليبية. فله منا كل الود والاحترام والتقدير.

استطلاع قيم استاذي الفاضل
شكرا جزيلا أستاذة نادية